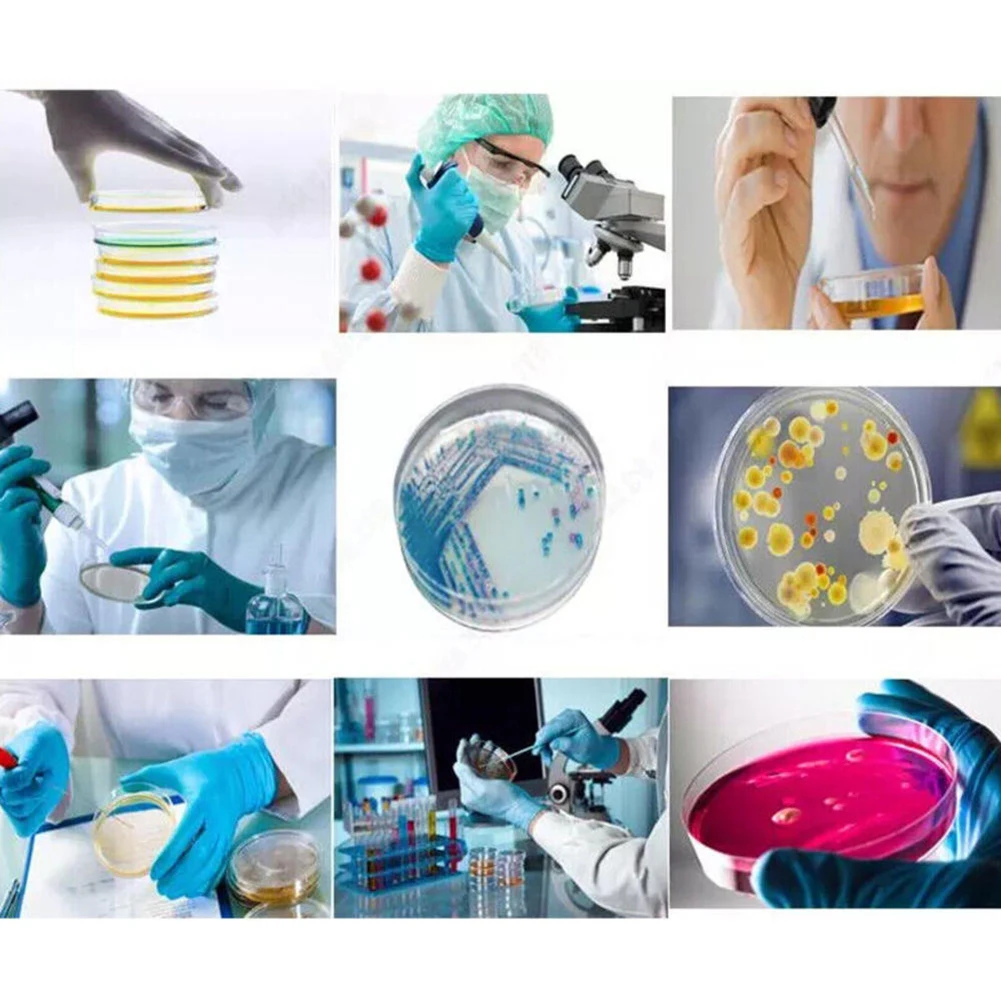
thumb

Пластиковые чаши Петри с 50 прозрачными биологическими чашками Петри для выращивания растений
График изменения цены & курс обмена валют
Пользователи также просматривали

$3.50
Led Mini Flashlight High , 6 Lighting , Usb Rechargeable Small Flashlight With Side Cob Light Abs Shell Magnetic With Lampshade
temu.com
$0.59
Spray Can Empty DIY Aerosol for Paint Graffiti Trays Painting Tinplate Supply Small
aliexpress.com
$1.45
4 Pcs Pitching Weighted Balls Sponge Kids Baseball Toys Practice Training Baseballs Soft Yellow Child
aliexpress.com
$115.11
Tool Chest, 5 Drawers Tool Storage Cabinet with Universal Lockable Wheels, Detachable Top Toolbox, Lock Bar, Protective Liner
aliexpress.com$37.18
Винтажные прямые джинсы с высокой посадкой для женщин - универсальная нить, черные, 18, короткие, Черный
shopozz.ru$166.51
Куртка-пальто Free People Lucy в стиле милитари с необработанным подолом и коричневым воротником, необычная , НОВИНКА, Brown taupe light pink
shopozz.ru$299.56
МУЖСКИЕ КРОССОВКИ NIKE AIR MAX 90 SE NYLON SUEDE Bucktan/Velvet Brown DZ5175-200, Коричневый, Nike Air Max 90
shopozz.ru$48.37
Женское темно-синее шифоновое мини-платье MSK для коктейлей и вечеринок BHFO 8549, Navy
shopozz.ru$40.91
Футболка Puma Mr Doodle X Short Sleeve Polo женская белая повседневная 530660-02, Белый
shopozz.ru$416.45
Оригинальные рабочие ботинки Justin, черные мужские рабочие ботинки Tanker, 11 дюймов, со стальным носком, размер S, Коричневый, Justin Original Workboots Tanker Black 11 Inch Electrical Steel T
shopozz.ru
$7.46
Forehead Cross With Pierced Ears Hoodie Nationality Small Cap Base Cap Multicolor Ramadan Home Hat Without A Mask
us.wholee.sale
$6.99
Air Fryer Mat Reusable Silicone Air Fryer Liner For Steamer Basket Perforated Silicone Mats Heat-Resistant Pads For Air Fryer
aliexpress.ru
$5.99
2022 Autumn Winter Women's Floral Graphic Patterned Daily T Shirts Tee Long Sleeve Abstract Print V Neck Fashion Tops New Shirt
aliexpress.ru
$3.82
Glass Drill Bit 1/4 Hex Shank Cross Tile Bits 6/8/10/12 mm Twist Drill Bit Glass Ceramic Concrete Hole Opener
aliexpress.com
$12.10
Women Wild Flower Hipster Casual Ladies Short Sleeve Funny Summer Tee Letters Top Gray T-Shirt
aliexpress.com
$42.50
Women Metal Legs Designer Optical Eyeglasses Prescription Acetate Rim Spectacles for Women Eyewear Glasses Frame Fashion Styles
aliexpress.com
$119.75
Drama Games of Throness Winterfell Castle Dragon MOC-39717 Figures Model Building Blocks Bricks Diy Toy Gift
aliexpress.com
$39.61
Vintage Chinese Ceramic Crafts Decoration Backflow Incense Burner Buddhism Zen Home Aromatherapy Ornaments
aliexpress.com
$6.10
Cotton Newborn Baby Clothes Toddler Girls Sleeveless Stripe Print Jumpsuit Infant Kids Clothing Autumn Baby Boy Girl Rompers
aliexpress.com
$2.09
USB Ionizer Rotatable Mini Auto Car Accessory Air Purifier Oxygen Bar Car Interior Decoration Home Air Freshener
aliexpress.com
$176.00
100% Cotton Bedlinen Luxury bedclothes King Queen Double Size Flower Printed Bedcover Duvet Cover Pillowcase Bedding Set
aliexpress.com
$480.56
Beech children's bed splicing queen bed with guardrail single girl widened baby bedside solid wood
aliexpress.com